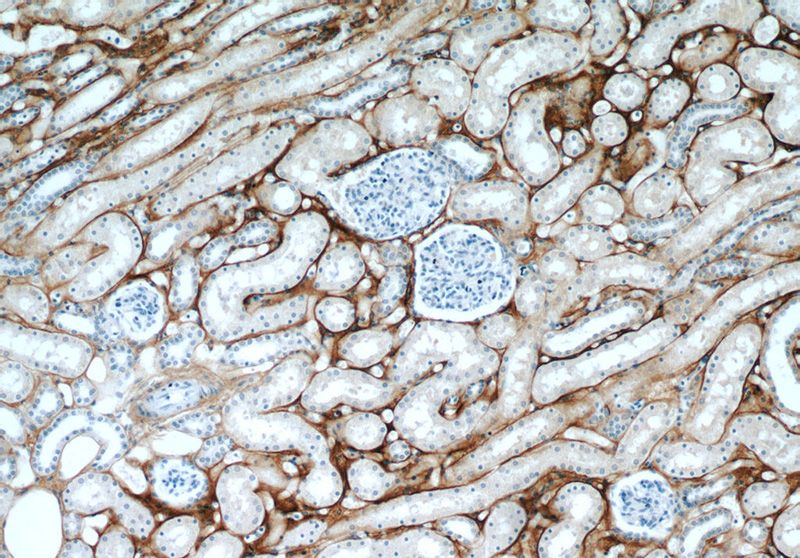
Immunohistochemical of paraffin-embedded human kidney using Catalog No:107621(BIGH3 antibody) at dilution of 1:50 (under 10x lens)

-
Product Name
TGFBI / BIGH3 antibody
- Documents
-
Description
TGFBI / BIGH3 Mouse Monoclonal antibody. Positive WB detected in LEC cells. Positive IP detected in HeLa cells. Positive IHC detected in human kidney tissue, human pancreas cancer tissue, human skin tissue. Observed molecular weight by Western-blot: 68 kDa
-
Tested applications
ELISA, IHC, WB, IP
-
Species reactivity
Human, Mouse; other species not tested.
-
Alternative names
Beta ig h3 antibody; BIGH3 antibody; CDB1 antibody; CDG2 antibody; CDGG1 antibody; CSD antibody; CSD1 antibody; CSD2 antibody; CSD3 antibody; EBMD antibody; Kerato epithelin antibody; LCD1 antibody; RGD CAP antibody; TGFBI antibody
-
Isotype
Mouse IgG2a
-
Preparation
This antibody was obtained by immunization of TGFBI / BIGH3 recombinant protein (Accession Number: NM_000358). Purification method: Caprylic acid/ammonium sulfate precipitation.
-
Clonality
Monoclonal
-
Formulation
PBS with 0.1% sodium azide and 50% glycerol pH 7.3.
-
Storage instructions
Store at -20℃. DO NOT ALIQUOT
-
Applications
Recommended Dilution:
WB: 1:200-1:2000
IP: 1:200-1:1000
IHC: 1:20-1:200
-
Validations

WB detection of anti-TGFBI in the extracellularmedia of LEC grown for 24 h under normoxia (N), hypoxia (H) or hypoxia and reoxygenation (H/N) for 6 h. One result representative of at least three different experiments is shown. Silver staining of the membranes was used as loading control. (From PMID:18560760; Irigoyen M, et al, TGFbeta-induced protein mediates lymphatic endothelial cell adhesion to the extracellular matrix under low oxygen conditions, Cell Mol Life Sci. 65(14), 2244-55, 2008)
Immunohistochemical of paraffin-embedded human kidney using Catalog No:107621(BIGH3 antibody) at dilution of 1:50 (under 10x lens)

Immunohistochemical of paraffin-embedded human kidney using Catalog No:107621(BIGH3 antibody) at dilution of 1:50 (under 40x lens)

IP Result of anti-BIGH3 (IP:Catalog No:107621, 4ug; Detection:Catalog No:107621 1:300) with HeLa cells lysate 1200ug.
-
Background
TGFBI, also named as BIGH3, Kerato-epithelin and RGD-CAP, binds to type I, II, and IV collagens. TGFBI is an adhesion protein which may play an important role in cell-collagen interactions. In cartilage, it may be involved in endochondral bone formation. TGFBI is an extracellular matrix adaptor protein, it has been reported to be differentially expressed in transformed tissues. TGFBI is a predictive factor of the response to chemotherapy, and suggest the use of TGFBI-derived peptides as possible therapeutic adjuvants for the enhancement of responses to chemotherapy.(PMID:20509890) Defects in TGFBI are the cause of epithelial basement membrane corneal dystrophy (EBMD). Defects in TGFBI are the cause of corneal dystrophy Groenouw type 1 (CDGG1). Defects in TGFBI are the cause of corneal dystrophy lattice type 1 (CDL1). Defects in TGFBI are a cause of corneal dystrophy Thiel-Behnke type (CDTB). Defects in TGFBI are the cause of Reis-Buecklers corneal dystrophy (CDRB). Defects in TGFBI are the cause of lattice corneal dystrophy type 3A (CDL3A). Defects in TGFBI are the cause of Avellino corneal dystrophy (ACD).
-
References
- Ge H, Cao W, Leng F, Chen W, Liu P, Chen W. Modified BIGH3 with an RGDRGD motif promotes human corneal epithelial cell adhesion and migration in vitro. Current eye research. 33(3):215-23. 2008.
- Irigoyen M, Ansó E, Salvo E, Dotor de las Herrerías J, Martínez-Irujo JJ, Rouzaut A. TGFbeta-induced protein mediates lymphatic endothelial cell adhesion to the extracellular matrix under low oxygen conditions. Cellular and molecular life sciences : CMLS. 65(14):2244-55. 2008.
- Ween MP, Lokman NA, Hoffmann P, Rodgers RJ, Ricciardelli C, Oehler MK. Transforming growth factor-beta-induced protein secreted by peritoneal cells increases the metastatic potential of ovarian cancer cells. International journal of cancer. 128(7):1570-84. 2011.
- Annis DS, Ma H, Balas DM. Absence of Vitamin K-Dependent γ-Carboxylation in Human Periostin Extracted from Fibrotic Lung or Secreted from a Cell Line Engineered to Optimize γ-Carboxylation. PloS one. 10(8):e0135374. 2015.
Related Products / Services
Please note: All products are "FOR RESEARCH USE ONLY AND ARE NOT INTENDED FOR DIAGNOSTIC OR THERAPEUTIC USE"
